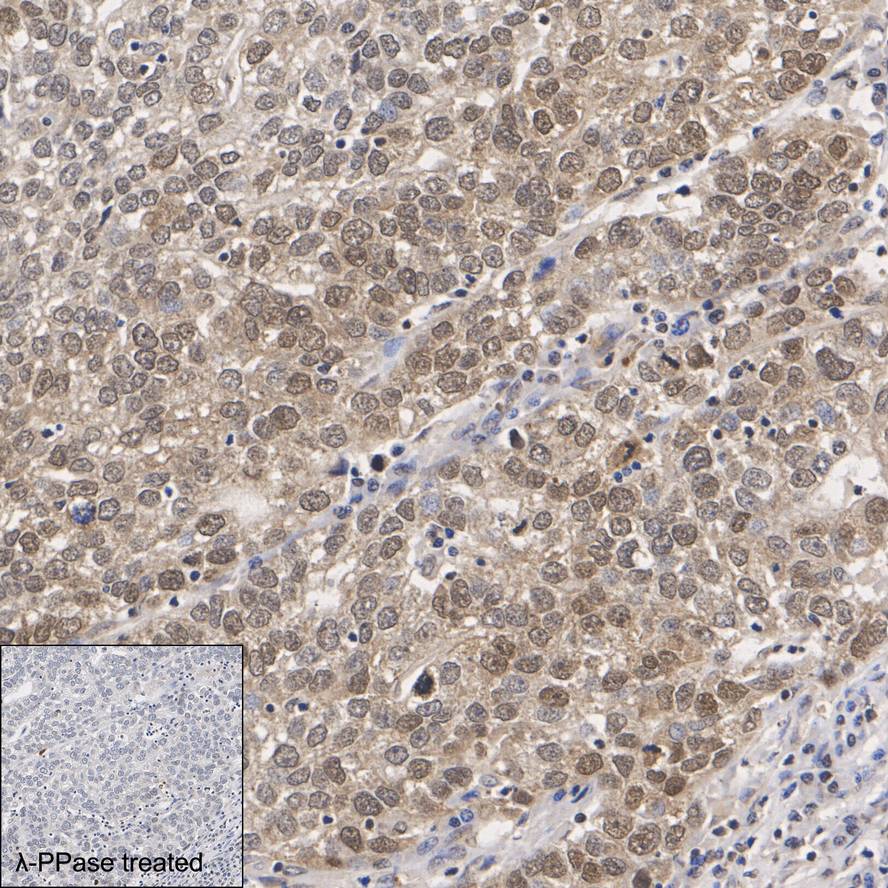

RMB: 699 特惠 1600 1600
产品规格
Catalog# HA723628
Phosphothreonine Recombinant Rabbit Monoclonal Antibody [PSH14-34]
-
WB
-
IHC-P
-
IF-Cell
-
IP
-
ELISA
-
Human
-
Mouse
-
Rat
-
Species independent
-
HA751516
不含抗保成分
-
unconjugated
概述
产品名称
Phosphothreonine Recombinant Rabbit Monoclonal Antibody [PSH14-34]
抗体类型
Recombinant Rabbit monoclonal Antibody
种属反应性
Human, Mouse, Rat, Species independent
验证应用
WB, IHC-P, IF-Cell, IP, ELISA
阳性对照
HeLa treated with 100nM Calyculin A for 30 minutes cell lysate, NIH/3T3 starved for 24 hours then treated with 100nM Calyculin A for 30 minutes cell lysate, PC-12 starved for 24 hours then treated with 100nM Calyculin A for 30 minutes cell lysate, human gastric cancer tissue, human prostate tissue, human colon tissue, human liver tissue, human testis tissue, mouse prostate tissue, mouse colon tissue, mouse liver tissue, mouse testis tissue, rat colon tissue, rat liver tissue, rat testis tissue, HeLa, NIH/3T3, PC-12.
偶联
unconjugated
克隆号
PSH14-34
反应性数据
Tested 已验证(内部验证通过)
Published 文献已报道(未内部验证,但有文献支持)
Predicted 预测可反应(基于高同源性)
Not recommended 不推荐(内部验证未通过)
| WB | IHC-P | IF-Cell | IP | ELISA | |
|---|---|---|---|---|---|
| Human |
|
|
|
||
| Mouse |
|
|
|
|
|
| Rat |
|
|
|
|
|
| Species Independent |
|
产品特性
形态
Liquid
浓度
存放说明
Shipped at 4℃. Store at +4℃ short term (1-2 weeks). It is recommended to aliquot into single-use upon delivery. Store at -20℃ long term.
存储缓冲液
1*PBS (pH7.4), 0.1% BSA, 40% Glycerol, 0.2% Proclean 950.
亚型
IgG
纯化方式
Protein A affinity purified.
应用稀释度
-
WB
-
1:5,000
-
IHC-P
-
1:1,000-1:8,000
-
IF-Cell
-
1:50,000
-
IP
-
1-2μg/sample
靶点
功能
Phosphorylation of threonine residues is associated with many growth factors and oncogene protein kinases, and is important for cell signaling in activation, proliferation and differentiation. Protein phosphorylation and dephosphorylation are basic mechanisms for the modification of protein function in eukaryotic cells. Phosphorylation is a rare post-translational event in normal tissue, however, the abundance of phosphorylated cellular proteins increases several fold following various activation processes which are mediated through phosphotyrosine, phosphoserine or phosphothreonine (p-tyr/p-ser/p-thr). Many signal transduction pathways, such as the EGF, PDGF and insulin receptor systems, contain tyr/ser/thr kinase which phosphorylate specific tyr/ser/thr residues upon binding of ligands to their receptors. T cell antigen receptor complex or the receptors for some hemopoietic growth factors may stimulate these phosphorylation associated kinases, and cells transformed by viral oncogenes contain elevated levels of phosphorylated tyr/ser/thr. An understanding of transformation by oncogenes and mitogenic processes of growth factors depends on the identification of their substrate and a subsequent determination of how phosphorylation affects their properties. Studies on the role of phosphorylated proteins have been hampered by their low abundance and the problem of distinguishing the various types of phosphorylated proteins. The most common procedure is to label intact cells or small tissue fragments with 32P and subsequently to isolate 32P labeled proteins by conventional biochemical methods. In order to identify the specific amino acids that undergo phosphorylation, additional long and tedious procedures for phosphoamino acid analysis are required. Immunoblotting of cellular proteins with antibodies directed against phosphoamino acids is advantageous as it does not involve 32P labeling, and can therefore be employed to monitor alterations in phosphorylation of specific proteins as they occur in intact organs or the whole animal.
背景文献
暂无
图片
-

☑ Cell treatment (CT)
Western blot analysis of Phosphothreonine on different lysates with Rabbit anti-Phosphothreonine antibody (HA723628) at 1/5,000 dilution.
Lane 1: HeLa cell lysate (20 µg/Lane)
Lane 2: HeLa treated with 100nM Calyculin A for 30 minutes cell lysate (20 µg/Lane)
Observed band size: Mutiple kDa
Exposure time: 59 seconds; ECL: K1801;
4-20% SDS-PAGE gel.
Proteins were transferred to a PVDF membrane and blocked with 5% NFDM/TBST for 1 hour at room temperature. The primary antibody (HA723628) at 1/5,000 dilution was used in primary antibody dilution (K1803) at 4℃ overnight. Goat Anti-Rabbit IgG - HRP Secondary Antibody (HA1001) at 1/50,000 dilution was used for 1 hour at room temperature. -

☑ Cell treatment (CT)
Western blot analysis of Phosphothreonine on different lysates with Rabbit anti-Phosphothreonine antibody (HA723628) at 1/5,000 dilution.
Lane 1: NIH/3T3 cell lysate
Lane 2: NIH/3T3 starved for 24 hours then treated with 100nM Calyculin A for 30 minutes cell lysate
Lane 3: NIH/3T3 starved for 24 hours then treated with 100nM Calyculin A for 30 minutes cell lysate, then the membrane treated with λpp for 1 hour
Lane 4: NIH/3T3 cell lysate
Lane 5: NIH/3T3 treated with 1mM Sodium orthovanadate for 30 minutes cell lysate
Lysates/proteins at 20 µg/Lane.
Observed band size: Mutiple kDa
Exposure time: 20 seconds; ECL: K1801;
4-20% SDS-PAGE gel.
Proteins were transferred to a PVDF membrane and blocked with 5% NFDM/TBST for 1 hour at room temperature. The primary antibody (HA723628) at 1/5,000 dilution was used in primary antibody dilution (K1803) at 4℃ overnight. Goat Anti-Rabbit IgG - HRP Secondary Antibody (HA1001) at 1/50,000 dilution was used for 1 hour at room temperature. -

☑ Cell treatment (CT)
Western blot analysis of Phosphothreonine on different lysates with Rabbit anti-Phosphothreonine antibody (HA723628) at 1/5,000 dilution.
Lane 1: PC-12 cell lysate
Lane 2: PC-12 starved for 24 hours then treated with 100nM Calyculin A for 30 minutes cell lysate
Lysates/proteins at 20 µg/Lane.
Observed band size: Mutiple kDa
Exposure time: 6 seconds; ECL: K1801;
4-20% SDS-PAGE gel.
Proteins were transferred to a PVDF membrane and blocked with 5% NFDM/TBST for 1 hour at room temperature. The primary antibody (HA723628) at 1/5,000 dilution was used in primary antibody dilution (K1803) at 4℃ overnight. Goat Anti-Rabbit IgG - HRP Secondary Antibody (HA1001) at 1/50,000 dilution was used for 1 hour at room temperature. -
☑ Cell treatment (CT)
Immunohistochemical analysis of paraffin-embedded human gastric cancer tissue untreated / treated with λpp with Rabbit anti-Phosphothreonine antibody (HA723628) at 1/1,000 dilution.
The section was pre-treated using heat mediated antigen retrieval with Tris-EDTA buffer (pH 9.0) for 20 minutes. The tissues were blocked in 1% BSA for 20 minutes at room temperature, washed with ddH2O and PBS, and then probed with the primary antibody (HA723628) at 1/1,000 dilution for 1 hour at room temperature. The detection was performed using an HRP conjugated compact polymer system. DAB was used as the chromogen. Tissues were counterstained with hematoxylin and mounted with DPX. -

Immunohistochemical analysis of paraffin-embedded human prostate tissue with Rabbit anti-Phosphothreonine antibody (HA723628) at 1/1,000 dilution.
The section was pre-treated using heat mediated antigen retrieval with Tris-EDTA buffer (pH 9.0) for 20 minutes. The tissues were blocked in 1% BSA for 20 minutes at room temperature, washed with ddH2O and PBS, and then probed with the primary antibody (HA723628) at 1/1,000 dilution for 1 hour at room temperature. The detection was performed using an HRP conjugated compact polymer system. DAB was used as the chromogen. Tissues were counterstained with hematoxylin and mounted with DPX. -

Immunohistochemical analysis of paraffin-embedded human colon tissue with Rabbit anti-Phosphothreonine antibody (HA723628) at 1/3,000 dilution.
The section was pre-treated using heat mediated antigen retrieval with Tris-EDTA buffer (pH 9.0) for 20 minutes. The tissues were blocked in 1% BSA for 20 minutes at room temperature, washed with ddH2O and PBS, and then probed with the primary antibody (HA723628) at 1/3,000 dilution for 1 hour at room temperature. The detection was performed using an HRP conjugated compact polymer system. DAB was used as the chromogen. Tissues were counterstained with hematoxylin and mounted with DPX. -

Immunohistochemical analysis of paraffin-embedded human liver tissue with Rabbit anti-Phosphothreonine antibody (HA723628) at 1/8,000 dilution.
The section was pre-treated using heat mediated antigen retrieval with Tris-EDTA buffer (pH 9.0) for 20 minutes. The tissues were blocked in 1% BSA for 20 minutes at room temperature, washed with ddH2O and PBS, and then probed with the primary antibody (HA723628) at 1/5,000 dilution for 1 hour at room temperature. The detection was performed using an HRP conjugated compact polymer system. DAB was used as the chromogen. Tissues were counterstained with hematoxylin and mounted with DPX. -

Immunohistochemical analysis of paraffin-embedded human testis tissue with Rabbit anti-Phosphothreonine antibody (HA723628) at 1/8,000 dilution.
The section was pre-treated using heat mediated antigen retrieval with Tris-EDTA buffer (pH 9.0) for 20 minutes. The tissues were blocked in 1% BSA for 20 minutes at room temperature, washed with ddH2O and PBS, and then probed with the primary antibody (HA723628) at 1/5,000 dilution for 1 hour at room temperature. The detection was performed using an HRP conjugated compact polymer system. DAB was used as the chromogen. Tissues were counterstained with hematoxylin and mounted with DPX. -

Immunohistochemical analysis of paraffin-embedded mouse prostate tissue with Rabbit anti-Phosphothreonine antibody (HA723628) at 1/1,000 dilution.
The section was pre-treated using heat mediated antigen retrieval with Tris-EDTA buffer (pH 9.0) for 20 minutes. The tissues were blocked in 1% BSA for 20 minutes at room temperature, washed with ddH2O and PBS, and then probed with the primary antibody (HA723628) at 1/1,000 dilution for 1 hour at room temperature. The detection was performed using an HRP conjugated compact polymer system. DAB was used as the chromogen. Tissues were counterstained with hematoxylin and mounted with DPX. -

Immunohistochemical analysis of paraffin-embedded mouse colon tissue with Rabbit anti-Phosphothreonine antibody (HA723628) at 1/8,000 dilution.
The section was pre-treated using heat mediated antigen retrieval with Tris-EDTA buffer (pH 9.0) for 20 minutes. The tissues were blocked in 1% BSA for 20 minutes at room temperature, washed with ddH2O and PBS, and then probed with the primary antibody (HA723628) at 1/5,000 dilution for 1 hour at room temperature. The detection was performed using an HRP conjugated compact polymer system. DAB was used as the chromogen. Tissues were counterstained with hematoxylin and mounted with DPX. -

Immunohistochemical analysis of paraffin-embedded mouse liver tissue with Rabbit anti-Phosphothreonine antibody (HA723628) at 1/3,000 dilution.
The section was pre-treated using heat mediated antigen retrieval with Tris-EDTA buffer (pH 9.0) for 20 minutes. The tissues were blocked in 1% BSA for 20 minutes at room temperature, washed with ddH2O and PBS, and then probed with the primary antibody (HA723628) at 1/3,000 dilution for 1 hour at room temperature. The detection was performed using an HRP conjugated compact polymer system. DAB was used as the chromogen. Tissues were counterstained with hematoxylin and mounted with DPX. -

Immunohistochemical analysis of paraffin-embedded mouse testis tissue with Rabbit anti-Phosphothreonine antibody (HA723628) at 1/3,000 dilution.
The section was pre-treated using heat mediated antigen retrieval with Tris-EDTA buffer (pH 9.0) for 20 minutes. The tissues were blocked in 1% BSA for 20 minutes at room temperature, washed with ddH2O and PBS, and then probed with the primary antibody (HA723628) at 1/3,000 dilution for 1 hour at room temperature. The detection was performed using an HRP conjugated compact polymer system. DAB was used as the chromogen. Tissues were counterstained with hematoxylin and mounted with DPX. -

Immunohistochemical analysis of paraffin-embedded rat colon tissue with Rabbit anti-Phosphothreonine antibody (HA723628) at 1/8,000 dilution.
The section was pre-treated using heat mediated antigen retrieval with Tris-EDTA buffer (pH 9.0) for 20 minutes. The tissues were blocked in 1% BSA for 20 minutes at room temperature, washed with ddH2O and PBS, and then probed with the primary antibody (HA723628) at 1/5,000 dilution for 1 hour at room temperature. The detection was performed using an HRP conjugated compact polymer system. DAB was used as the chromogen. Tissues were counterstained with hematoxylin and mounted with DPX. -

Immunohistochemical analysis of paraffin-embedded rat liver tissue with Rabbit anti-Phosphothreonine antibody (HA723628) at 1/8,000 dilution.
The section was pre-treated using heat mediated antigen retrieval with Tris-EDTA buffer (pH 9.0) for 20 minutes. The tissues were blocked in 1% BSA for 20 minutes at room temperature, washed with ddH2O and PBS, and then probed with the primary antibody (HA723628) at 1/5,000 dilution for 1 hour at room temperature. The detection was performed using an HRP conjugated compact polymer system. DAB was used as the chromogen. Tissues were counterstained with hematoxylin and mounted with DPX. -

Immunohistochemical analysis of paraffin-embedded rat testis tissue with Rabbit anti-Phosphothreonine antibody (HA723628) at 1/8,000 dilution.
The section was pre-treated using heat mediated antigen retrieval with Tris-EDTA buffer (pH 9.0) for 20 minutes. The tissues were blocked in 1% BSA for 20 minutes at room temperature, washed with ddH2O and PBS, and then probed with the primary antibody (HA723628) at 1/5,000 dilution for 1 hour at room temperature. The detection was performed using an HRP conjugated compact polymer system. DAB was used as the chromogen. Tissues were counterstained with hematoxylin and mounted with DPX. -

Indirect ELISA analysis of Phosphothreonine.
-

Immunocytochemistry analysis of HeLa cells untreated / treated with 100nM Calyculin A for 30 minutes labeling Phosphothreonine with Rabbit anti-Phosphothreonine antibody (HA723628) at 1/50,000 dilution.
Cells were fixed in 4% paraformaldehyde for 15 minutes at room temperature, permeabilized with 0.1% Triton X-100 in PBS for 15 minutes at room temperature, then blocked with 1% BSA in 10% negative goat serum for 1 hour at room temperature. Cells were then incubated with Rabbit anti-Phosphothreonine antibody (HA723628) at 1/50,000 dilution in 1% BSA in PBST overnight at 4 ℃. Goat Anti-Rabbit IgG H&L (iFluor™ 488, HA1121) was used as the secondary antibody at 1/1,000 dilution. PBS instead of the primary antibody was used as the secondary antibody only control. Nuclear DNA was labelled in blue with DAPI.
Beta tubulin (HA601187, red) was stained at 1/100 dilution overnight at +4℃. Goat Anti-Mouse IgG H&L (iFluor™ 594, HA1126) was used as the secondary antibody at 1/1,000 dilution. -

Immunocytochemistry analysis of NIH/3T3 cells untreated / starved for 24 hours then treated with 100nM Calyculin A for 30 minutes labeling Phosphothreonine with Rabbit anti-Phosphothreonine antibody (HA723628) at 1/50,000 dilution.
Cells were fixed in 4% paraformaldehyde for 15 minutes at room temperature, permeabilized with 0.1% Triton X-100 in PBS for 15 minutes at room temperature, then blocked with 1% BSA in 10% negative goat serum for 1 hour at room temperature. Cells were then incubated with Rabbit anti-Phosphothreonine antibody (HA723628) at 1/50,000 dilution in 1% BSA in PBST overnight at 4 ℃. Goat Anti-Rabbit IgG H&L (iFluor™ 488, HA1121) was used as the secondary antibody at 1/1,000 dilution. PBS instead of the primary antibody was used as the secondary antibody only control. Nuclear DNA was labelled in blue with DAPI.
Beta tubulin (HA601187, red) was stained at 1/100 dilution overnight at +4℃. Goat Anti-Mouse IgG H&L (iFluor™ 594, HA1126) was used as the secondary antibody at 1/1,000 dilution. -

Immunocytochemistry analysis of PC-12 cells untreated / starved for 24 hours then treated with 100nM Calyculin A for 30 minutes labeling Phosphothreonine with Rabbit anti-Phosphothreonine antibody (HA723628) at 1/50,000 dilution.
Cells were fixed in 4% paraformaldehyde for 15 minutes at room temperature, permeabilized with 0.1% Triton X-100 in PBS for 15 minutes at room temperature, then blocked with 1% BSA in 10% negative goat serum for 1 hour at room temperature. Cells were then incubated with Rabbit anti-Phosphothreonine antibody (HA723628) at 1/50,000 dilution in 1% BSA in PBST overnight at 4 ℃. Goat Anti-Rabbit IgG H&L (iFluor™ 488, HA1121) was used as the secondary antibody at 1/1,000 dilution. PBS instead of the primary antibody was used as the secondary antibody only control. Nuclear DNA was labelled in blue with DAPI.
Beta tubulin (HA601187, red) was stained at 1/100 dilution overnight at +4℃. Goat Anti-Mouse IgG H&L (iFluor™ 594, HA1126) was used as the secondary antibody at 1/1,000 dilution. -

Phosphothreonine was immunoprecipitated from 0.2 mg NIH/3T3 starved for 24 hours then treated with 100nM Calyculin A for 30 minutes cell lysate with HA723628 at 2 µg/10 µl beads. Western blot was performed from the immunoprecipitate using HA723628 at 1/5,000 dilution. HRP Conjugated Anti-Rabbit IgG for IP Nano-secondary antibody at 1/5,000 dilution was used for 1 hour at room temperature.
Lane 1: NIH/3T3 starved for 24 hours then treated with 100nM Calyculin A for 30 minutes cell lysate (input)
Lane 2: HA723628 IP in NIH/3T3 starved for 24 hours then treated with 100nM Calyculin A for 30 minutes cell lysate
Lane 3: Rabbit IgG instead of HA723628 in NIH/3T3 starved for 24 hours then treated with 100nM Calyculin A for 30 minutes cell lysate
Blocking/Dilution buffer: 5% NFDM/TBST
Exposure time: 20 seconds; ECL: K1801 -

Phosphothreonine was immunoprecipitated from 0.2 mg PC-12 starved for 24 hours then treated with 100nM Calyculin A for 30 minutes cell lysate with HA723628 at 2 µg/10 µl beads. Western blot was performed from the immunoprecipitate using HA723628 at 1/5,000 dilution. HRP Conjugated Anti-Rabbit IgG for IP Nano-secondary antibody at 1/5,000 dilution was used for 1 hour at room temperature.
Lane 1: PC-12 starved for 24 hours then treated with 100nM Calyculin A for 30 minutes cell lysate (input)
Lane 2: HA723628 IP in PC-12 starved for 24 hours then treated with 100nM Calyculin A for 30 minutes cell lysate
Lane 3: Rabbit IgG instead of HA723628 in PC-12 starved for 24 hours then treated with 100nM Calyculin A for 30 minutes cell lysate
Blocking/Dilution buffer: 5% NFDM/TBST
Exposure time: 25 seconds; ECL: K1801
请注意: All products are "FOR RESEARCH USE ONLY AND ARE NOT INTENDED FOR DIAGNOSTIC OR THERAPEUTIC USE"



 浙公网安备 33019202000643号
浙公网安备 33019202000643号